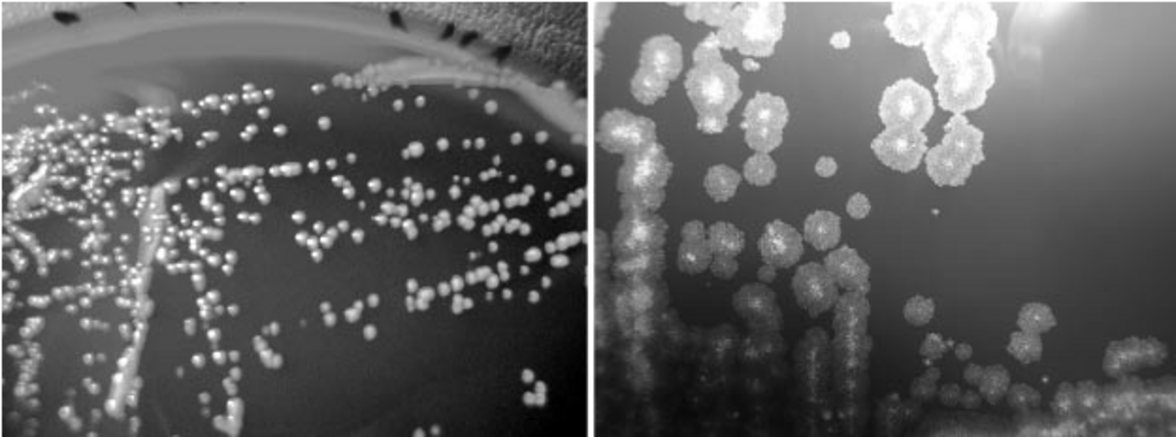
Рекомендации избегания водопроводной воды уменьшает уровень больничной заболеваемости, вызванной легочными нетуберкулезными микобактериями

Внедрение протокола избегания использования водопроводной воды в четырех отделениях больницы при университете Дьюка сократило уровень легочных нетуберкулезных микобактерий на 76%, согласно данным исследования, опубликованным в журнале Clinical Infectious Diseases.
Рекомендации "успешно смягчили вспышку легочного микобактериальных абсцессов" в больнице, сообщил Артур В. Бейкер, доцент кафедры инфекционных болезней Школы медицины Дьюкского университета. "Основным нововведением было использование стерильной воды вместо водопроводной для ухода за пациентами из группы высокого риска, например, за пациентами с трансплантацией легких".
По словам Бейкера, в конце мая 2014 года для всех пациентов в трех отделениях интенсивной терапии и в одном промежуточном отделении был введен протокол избегания использования водопроводной воды.
"В этих четырех отделениях стерильная вода заменяла водопроводную для таких рутинных действий, как уход за полостью рта и ополаскивание катетеров", - пояснил он, добавив, что пациенты были ограничены в принятии душа, а купание осуществлялось при помощи безводных средств или стерильной водой.
Согласно исследованию, Бейкер и его коллеги ретроспективно идентифицировали всех пациентов, имеющих положительные культуры на нетуберкулезные микобактерии (НТМ) с начала вспышки M. abscessus в августе 2013 г. по декабрь 2015 г. для оценки эффективности протокола. Также были проведены исследования культур микобактерий на биопленках из водопроводных кранов, душевых насадок, машин для льда и водяных баков.
Исследование показало, что за 29-месячный период у 105 пациентов было выделено 137 изолятов НТМ дыхательных путей в четырех отделениях больницы. По данным исследования, частота случаев выделения НТМ, включающего вид M. chelonae-M. immunogenum, M. avium complex, M. gordonae и M. abscessus, снизилась с 41 эпизода на 10 000 больничных дней за 10-месячный период до 9,9 больных на 10 000 больничных дней за 19-месячный период действия протокола (IRR = 0,24; 95% CI, 0,17-0,34), - т.е. снижение составило 76%.
"Другие больницы с эндемическими НТМ, с новыми системами водоснабжения или с пациентами, подверженными высокому риску заражения НТМ, например, где есть реципиенты для пересадки легких должны рассмотреть возможность внедрения аналогичных протоколов", - сказал Бейкер.